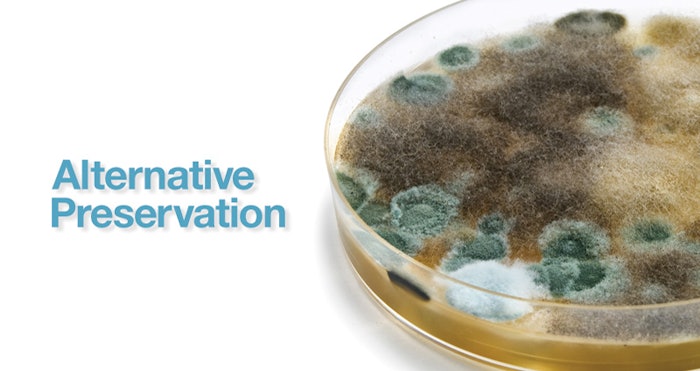

Log in to view the full article
Spectrastat G2-N is a natural, patented high-performing biostatic system of multifunctional ingredients that allows formulators to use hurdle technology to create self-preserving formulations. Spectrastat G2-N contains CHA, a novel chelating agent and organic acid that works at a wide range of pH. Spectrastat G2-N is broad spectrum and performs superbly at neutral pH and is acceptable for use in organic personal care products under NSF/ANSI 305-2012.
Spectrastat G2-N is an optimized multifunctional system that passes challenge tests every time.